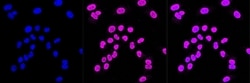
Invitrogen 14-3-3 gamma Recombinant Rabbit Monoclonal Antibody (23GB1970),

missing translation for 'onlineSavingsMsg'
Learn More
Learn More
Invitrogen™ 14-3-3 gamma Recombinant Rabbit Monoclonal Antibody (23GB1970), Invitrogen™
Descripción
14-3-3 gamma encodes a product that belongs to the 14-3-3 family of proteins which mediate signal transduction by binding to phosphoserine-containing proteins. This highly conserved protein family is found in both plants and mammals, and this protein is 100% identical to the rat ortholog. It is induced by growth factors in human vascular smooth muscle cells, and is also highly expressed in skeletal and heart muscles, suggesting an important role for this protein in muscle tissue. It has been shown to interact with RAF1 and protein kinase C, proteins involved in various signal transduction pathways.

Especificaciones
Especificaciones
| Antígeno | 14-3-3 gamma |
| Aplicaciones | Flow Cytometry, Western Blot, Immunocytochemistry |
| Clasificación | Recombinant Monoclonal |
| Clon | 23GB1970 |
| Concentración | 0.2 mg/mL |
| Conjugado | Unconjugated |
| Formulación | PBS with 50% glycerol and 0.02% sodium azide; pH 7.4 |
| génica | YWHAG |
| N.º de referencia del gen | P61981, P61982, P61983 |
| Alias de gen | 14-3-3 gamma; 14-3-3 protein gamma; 14-3-3 protein gamma subtype; 14-3-3 protein gamma, N-terminally processed; 14-3-3 protein gamma-1; 14-3-3 protein gamma-subtype; 14-3-3G; 14-3-3gamma; 3-monooxgenase/tryptophan 5-monooxgenase activation protein, gamma polypeptide; 3-monooxgenase/tryptophan 5-monooxygenase activation protein, gamma polypeptide; 3-monooxygenase/tryptophan 5-monooxgenase activation protein gamma polypeptide; 3-monooxygenase/tryptophan 5-monooxygenase activation protein, gamma polypeptide; 3-monooxygenase/tryptophan 5-monooxygenase activation protein, gamma polypeptide 1; cb47; D7Bwg1348e; fd20c02; hypothetical protein; KCIP-1; PPP1R170; Protein kinase C inhibitor protein 1; protein phosphatase 1, regulatory subunit 170; RCJMB04_5e12; tryosine 3-monooxgenase/tryptophan 5 monooxgenase activation protein gamma; tryosine 3-monooxgenase/tryptophan 5-monooxgenase activation protein gamma polypeptide; tyrosine 3/tryptophan 5 -monooxygenase activation protein gamma polypeptide; tyrosine 3/tryptophan 5 -monooxygenase activation protein, gamma polypeptide; tyrosine 3-monooxgenase/tryptophan 5-monooxgenase activation protein, gamma polypeptide; tyrosine 3-monooxygenase/tryptophan 5-monooxygenase activation protein gamma; tyrosine 3-monooxygenase/tryptophan 5-monooxygenase activation protein, gamma; tyrosine 3-monooxygenase/tryptophan 5-monooxygenase activation protein, gamma polypeptide; wu:fd20c02; wu:fj53d01; ywhag; ywhag1; zgc:73131 |
| Mostrar más |
Título del producto
Al hacer clic en Enviar, acepta que Fisher Scientific se ponga en contacto con usted en relación con los comentarios que ha proporcionado en este formulario. No compartiremos su información para ningún otro fin. Toda la información de contacto proporcionada se mantendrá de acuerdo con nuestra Política de Privacidad. Política de privacidad.
¿Detecta una oportunidad de mejora?